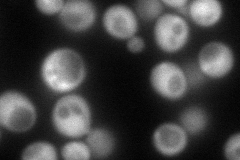
YEL039C
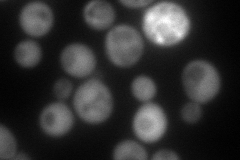
YEL039C
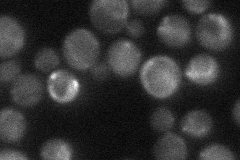
YEL039C
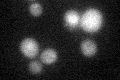
YEL039C

View description
Cytochrome c isoform 2, expressed under hypoxic conditions; electron carrier of the mitochondrial intermembrane space that transfers electrons from ubiquinone-cytochrome c oxidoreductase to cytochrome c oxidase during cellular respiration
Localization:
Intensity:
Fold change:
Significance:
-
C’ GFP library in SD

below threshold15.14 -
N' NOP1pr-GFP in SD
cytosol147.097 -
N' TEF2pr-mCherry in SD
cytosol131.53 -
N' NATIVEpr-GFP in SD
cytosol30.9636 -
N' TEF2pr-VC and Cyto-VN in SD

#N/A0 -
C’ GFP library in SD+DTT
cytosol15.371.01No -
C’ GFP library in SD+H2O2

cytosol13.310.87No -
C’ GFP library in Starvation Media

cytosol16.251.07No -
C’ GFP library on the background of Pup2-DaMP

below threshold -
C’ GFP library on the background of CCT mutant

below threshold15.060.994465No
